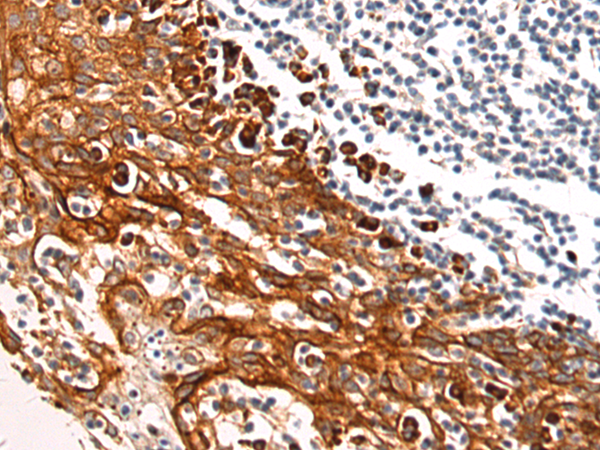

别名:PALML; C1orf11应用:IHC
反应种属:Human, Mouse, Rat
规格:50μl/100μl
| Description |
|---|
| Palmdelphin, encoded by PALMD gene, is a newly identified cytosolic isoform of paralemmin-1, a lipid raft-associated protein implicated in cell shape control. Paralemmin (Palm) is a prenyl-palmitoyl anchored membrane protein that can drive membrane and process formation in neurons. Previous finding suggest that palmdelphin may peripherally associate with endomembranes or cytoskeleton-linked structures. Palmdelphin appears to be 80 kDa in Western blotting, larger than the predicated of 63 kDa, and this may be due to the acidic nature of this protein or its posttranslational modification. |
| Specification | |
|---|---|
| Aliases | PALML; C1orf11 |
| Swissprot | Q9NP74 |
| Host/Isotype | Rabbit IgG |
| Storage | Store at 4°C short term. Aliquot and store at -20°C long term. Avoid freeze/thaw cycles. |
| Species Reactivity | Human, Mouse, Rat |
| Immunogen | Fusion protein of human PALMD |
| Formulation | pH7.4 PBS, 0.05% NaN3, 40% Glycerol |
| Application | |
|---|---|
| IHC | 1/100-1/300 |
| ELISA | 1/5000-1/10000 |
![]() |
The image is immunohistochemistry of paraffin-embedded Human liver cancer tissue using P03558(PALMD Antibody) at dilution 1/120. (Original magnification: ×200) |
![]() |
The image is immunohistochemistry of paraffin-embedded Human tonsil tissue using P03558(PALMD Antibody) at dilution 1/120. (Original magnification: ×200) |
本公司的所有产品仅用于科学研究或者工业应用等非医疗目的,不可用于人类或动物的临床诊断或治疗,非药用,非食用。
暂无评论
本公司的所有产品仅用于科学研究或者工业应用等非医疗目的,不可用于人类或动物的临床诊断或治疗,非药用,非食用。
中文

发表回复